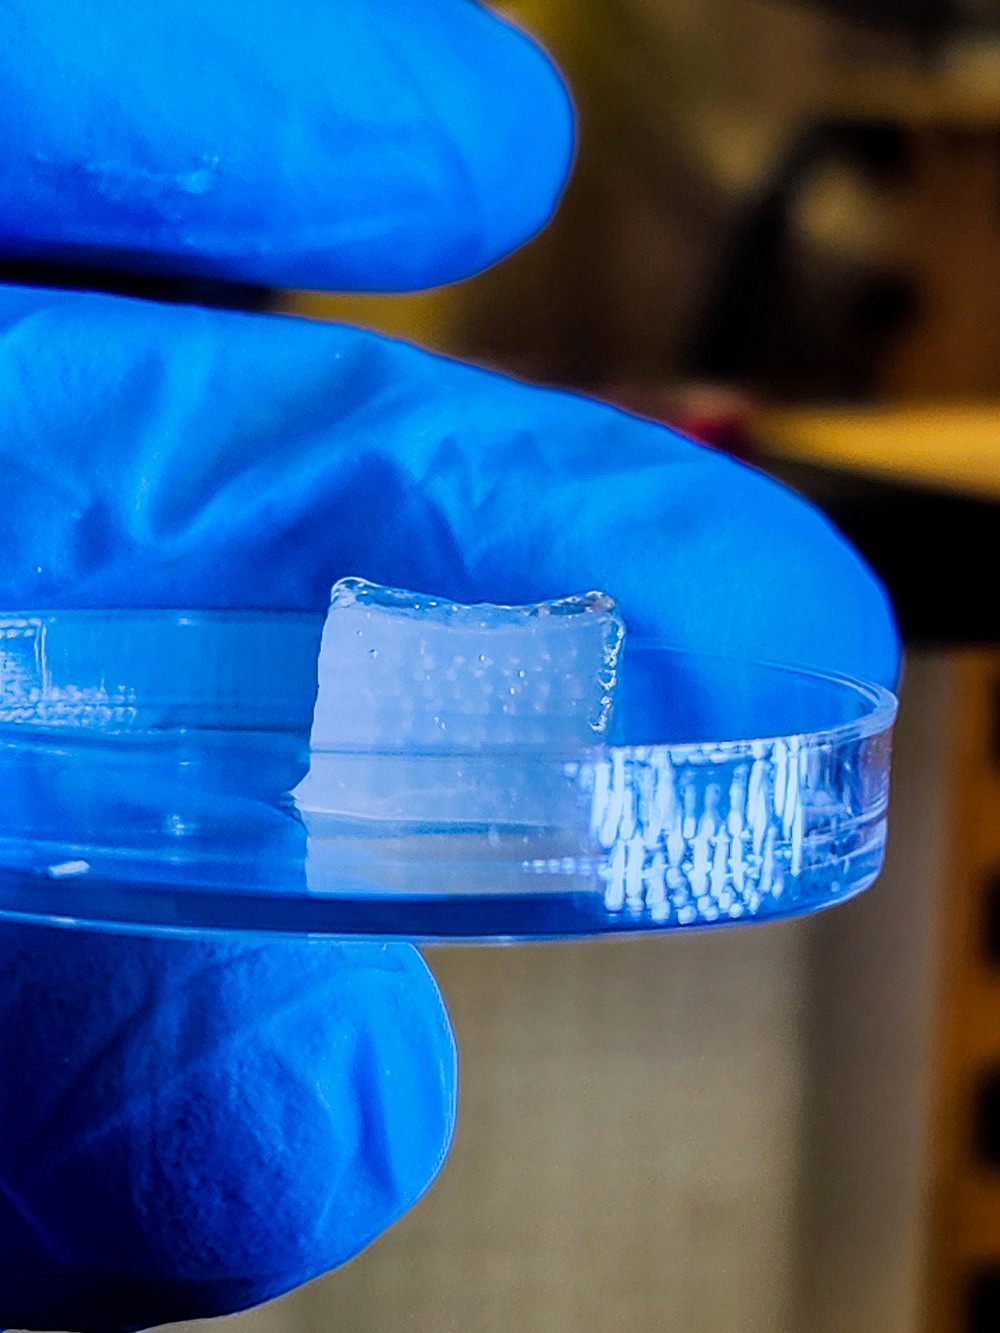
__wf_reserved_inherit

Bioprinting Breakthrough Creates Functional Tissue at Warp Speed
New technique brings us closer to scalable organ fabrication for transplantation and regenerative medicine
[Grok]
The promise of bioprinting has always felt like science fiction waiting to turn into science fact—a world where organs are printed on demand, disease models are tailored to individual patients, and tissue repair happens seamlessly in the operating room. But for years, the field has been hobbled by technical challenges: slow fabrication speeds, fragile cell structures, and the inability to match the dense, intricate architecture of human tissue. Now, a team of researchers at Penn State has smashed through these barriers, unveiling a high-speed, high-precision bioprinting technique that could redefine the limits of regenerative medicine.
The details, published in Nature Communications, are as ambitious as they are ingenious: a method that builds human tissue at speeds up to 10 times faster than existing technologies. The secret? Leveraging spheroids—dense clusters of living cells—to mimic the architecture of human tissue with unprecedented fidelity. It’s a tantalizing glimpse into a future where regenerative medicine can meet clinical demands on a global scale.
The Problem with Traditional Bioprinting
To understand the leap forward, one must first grapple with the status quo. Bioprinting today typically involves layering bioink—a mixture of living cells and hydrogel—into 3D structures. While effective in theory, this approach struggles to replicate the cell density of real human tissue, a crucial requirement for functionality and clinical application. Worse still, the printing process often damages delicate cellular structures, compromising the viability of the final product.
It’s not just about biology; it’s also about engineering. Previous methods have relied on painstakingly slow processes, like manually positioning spheroids one by one, making scalable tissue fabrication a logistical nightmare. “Think of it as trying to build a brick wall,” explains Ibrahim T. Ozbolat, lead researcher and Penn State professor. “The cells are the bricks, and the bioink is the mortar—but traditional tools are too clumsy to lay the bricks with the precision we need.”
A High-Throughput Revolution
This is where Penn State’s High-throughput Integrated Tissue Fabrication System for Bioprinting (HITS-Bio) enters the fray. The technology, which utilizes a digitally controlled array of nozzles, can manipulate multiple spheroids simultaneously, placing them with millimeter-scale accuracy. It’s like swapping out your clunky trowel for a robotic arm capable of assembling complex structures at lightning speed.
The results are staggering. Using a modest 4x4 nozzle array, researchers demonstrated the ability to place 16 spheroids at once, building a cubic centimeter of cartilage tissue—about 600 spheroids—in under 40 minutes. Compare that to previous techniques, which could take days for the same task. Moreover, cell viability remained above 90%, a critical metric for ensuring the tissue's functionality post-fabrication.
From Lab Bench to Operating Room
But the real showstopper? The team successfully tested their technology in a live surgical setting. Using microRNA technology to program spheroids into bone tissue, they printed living cells directly into a rat’s skull wound during surgery. Within just six weeks, the wound was 96% healed, a stunning demonstration of the platform’s potential for on-demand tissue repair.
Ozbolat and his colleagues are now eyeing even more ambitious applications. “We’ve proven the concept for cartilage and bone,” he says. “But the next frontier is vascularized tissue—think organs like the liver, where blood flow is critical to function.”
Implications and Future Directions
The implications are hard to overstate. By expanding the nozzle array, HITS-Bio could scale up to fabricate large, complex tissues at a fraction of the time and cost of existing methods. The potential applications are vast: from developing fully functional organs for transplantation to creating personalized disease models for drug testing.
Still, challenges remain. Incorporating blood vessels into bioprinted tissue will be crucial for creating fully functional organs, and the team is already at work on solutions. Yet even without these advancements, HITS-Bio represents a monumental step forward.
A Cautious Optimism
It’s tempting to imagine a future where organ shortages are a thing of the past, but history teaches us that such breakthroughs often bring their own set of challenges. Questions of ethical regulation, cost accessibility, and long-term tissue viability will need answers. But if Penn State’s latest innovations are any indication, the field is inching ever closer to making bioprinted tissues a cornerstone of modern medicine.
For now, the team’s work stands as a testament to what’s possible when engineering and biology converge with a dash of audacious ambition. As Ozbolat puts it, “This isn’t just about faster or better; it’s about rewriting the playbook for regenerative medicine.”


















